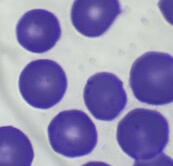
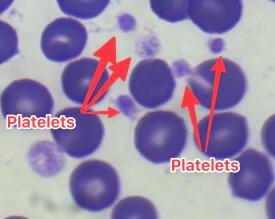
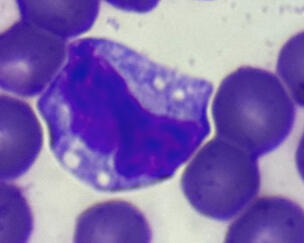

Haematology Guide
Navigation
Haematology
Haematology covers a broad range of topics, including the production of all cell types in blood) and laboratory assessment of hematopoietic cells.Abnormalities in the blood can provide clues to the presence of underlying diseases, such as inflammation, and can also be diagnostic in themselves, such as revealing a leukemia.

Red Blood Cells
Red blood cell morphology is species-dependent. There are also changes that occur in red blood cells that can give us clues as to underlying diseases. Some of these changes can be pathologic in one context (or in one species) or physiologic in another. For example, small Heinz bodies are commonly seen in the blood of cats without causing anemia. However, Heinz bodies in dog blood are always abnormal and indicate an oxidant-induced hemolytic anemia. In addition, the number or degree of change in the red blood cells are also important. For example, large numbers of spherocytes are typically seen an immune-mediated anemia. Although small numbers of spherocytes can be seen in an immune-mediated anemia, spherocytic-like cells are in low numbers with fragmentation injury and oxidant injury (called pyknocytes in this case). So, all red blood cell changes should be interpreted in the context of the case. For instance, low numbers of schistocytes may be more relevant in a sick dog with concurrent thrombocytopenia and suspect disseminated intravascular coagulation, than in a pre-surgical blood health check in a clinically normal dog. In this section, we will cover the following:

Platelets
Platelets
Renal tubular epithelial cells are not commonly found in urine and can be challenging to differentiate from transitional epithelial cells. The suspicion of a renal origin arises when large numbers of uniformly sized and shaped epithelial cells are observed in the urine. Renal tubular cells tend to be squarer or rectangular, with a blunt or squared-off end indicating a columnar shape, while transitional cells are rounder and more variable in size. Caudate cells, which have a tailed shape, are thought to line the renal pelvis or calyces. Columnar cells are more likely to come from the collecting ducts than from the upper renal tubules. The presence of moderate or high numbers of renal tubular epithelial cells in a urinalysis suggests renal tubular injury.



Neutrophils
Neutrophils
Mature (Segmented) Neutrophils
In healthy animals, only mature neutrophils are released into the circulation. In humans, these mature neutrophils have nuclei segmented into lobes. However, in many animal species, mature neutrophils do not have a distinct lobe but they are still referred to as segmented neutrophils.Immature (Band) Neutrophils
Immature neutrophils lack nuclear segmentation, with decreasing indentation with more immaturityToxic changes
Neutrophils with moderate toxic changes display (cytoplasmic basophilia (more blue), cytoplasmic vacuolation, increased Dohle bodies (small blue inclusion in cytoplasm) and lighter nucleus than normal).Function
Neutrophils are part of the innate immune system and defend against bacterial pathogens. They have a short half-life and typically only last for 10-15 hours once they are released.




Eosinophils
Eosinophils in dogs have round granules and a light blue cytoplasm. In contrast, eosinophils in cats have small rod-shaped orange granules that fill the cytoplasmIn most animals, eosinophil granules are orange. Generally, the nuclei of mature eosinophils are shorter and less segmented than those of neutrophils, and if visible, the cytoplasm is pale blue. Species variation exists regarding the number, size, and shape of eosinophil granules.The most significant intraspecies variation is observed in dog eosinophils. Marked variation in granule size, number, and shape can occur within and between individuals of any breed. A particular morphologic variant of eosinophils is commonly seen in Greyhounds, other sighthounds (such as Whippets and Deerhounds), and some Golden Retrievers. In these breeds, eosinophils lack visible granules and appear as cells with slightly segmented nuclei, gray cytoplasm, and vacuoles. They are sometimes mistaken for toxic neutrophils or monocytes and are called "vacuolated" or "gray" eosinophils.



Basophils
Canine basophils can be challenging to identify since many do not have readily visible granules. This is because the granules are a pale lavender color rather than purple. The key identifying features of canine basophils are their long and folded nucleus, which is often described as "ribbon-like," and the unusual gray to lavender hue of the cytoplasm. Some basophils may contain a few visible light purple granules, which are more apparent in cells that are ruptured. Basophils are generally rare in the blood of healthy dogs.
In contrast, feline basophils are packed with small, slightly oval granules that are also pale lavender in color rather than deep purple. In many feline basophils, the nucleus appears to have vacuoles, which are actually granules lying on top of the chromatin. Similar to dogs, basophils are rare in the blood of healthy cats.

Monocyte
Monocytes can be challenging to identify due to their variability in size and appearance. Their nucleus can range from round to kidney-shaped to pseudo-lobulated, which can sometimes resemble that of a neutrophil. In dogs, the nucleus can even be band-shaped, leading to confusion with band neutrophils. However, the chromatin of monocytes is less dense than that of neutrophils and has a lacey to slightly clumped appearance.The cytoplasm of monocytes is usually smooth and blue-grey, and may contain a few variably-sized vacuoles and occasionally a few very fine pink-red granules. The texture of monocyte cytoplasm is slightly grainy or coarse compared to the very smooth and glassy cytoplasm of lymphocytes.


Macrophage
Macrophages
Round, cells with a grainy texture and visible nuclei may be seen in urine, along with bacterial rods visible in the background. These cells can be classified based on the number seen per high-power field (HPF) as (none), (<5), (5-20), (20-100), or (>100). Up to 5 white blood cells (WBCs) per HPF are generally considered acceptable for "normal" urine, and are typically segmented neutrophils. WBCs may lyse in very alkaline or dilute urine (specific gravity <1.008). Compared to red blood cells (RBCs), WBCs are more grainy and larger. Compared to transitional epithelial cells, WBCs are smaller with rounder borders, while epithelial cells vary in size, are less grainy, and usually have eccentric nuclei.